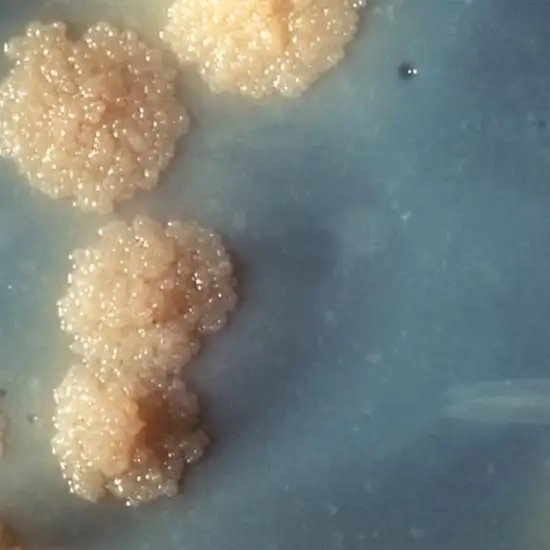

Book Mycobacterium Tuberculosis Culture Appointment Online Near me at the best price in Delhi/NCR from Ganesh Diagnostic. NABL & NABH Accredited Diagnostic centre and Pathology lab in Delhi offering a wide range of Radiology & Pathology tests. Get Free Ambulance & Free Home Sample collection. 24X7 Hour Open. Call Now at 011-47-444-444 to Book your Mycobacterium Tuberculosis Culture at 50% Discount.
A culture test examines bacteria by growing them on various substrates, and this is to ascertain the presence of specific bacteria. In the tuberculosis culture test instance, the objective is to determine the presence of the tuberculosis bacteria Mycobacterium tuberculosis.
Typically, the germs are isolated from a sputum sample collected from a patient suspected of having tuberculosis in their lungs. However, tuberculosis can manifest itself in different places of the body. When suspected of extrapulmonary tuberculosis (a disease that occurs outside the lungs), other clinical specimens such as urine can be submitted for evaluation. 1
Mycobacterium tuberculosis is called acid-fast bacilli (AFB) because of its ability to preserve the stain's colour following an acid wash. They can then be viewed through a microscope.
Someone has signs and symptoms of active TB or other mycobacterial lung infection, such as:
Symptoms of extrapulmonary TB or other mycobacterial infections vary depending on the location of the body affected. Back discomfort and paralysis (spinal TB), anaemia-induced weakness (TB bone marrow), changed mental state, headache, coma (TB meningitis), joint pain, and belly pain.
The lab Technician will provide details about the process.
>>No preparation is needed.
No particular type of care is required.
The Mycobacteria (TB) Culture Test cost varies by region and facility. So constantly get tested at trustworthy diagnostic centers like Ganesh Diagnostic. It is staffed by trained and experienced professionals to assure patient and visitor safety.
| Test Type | Mycobacterium Tuberculosis Culture |
| Includes | Mycobacterium Tuberculosis Culture Test (Physician) |
| Preparation | |
| Reporting | Within 24 hours* |
| Test Price |
₹ 750
|

Early check ups are always better than delayed ones. Safety, precaution & care is depicted from the several health checkups. Here, we present simple & comprehensive health packages for any kind of testing to ensure the early prescribed treatment to safeguard your health.